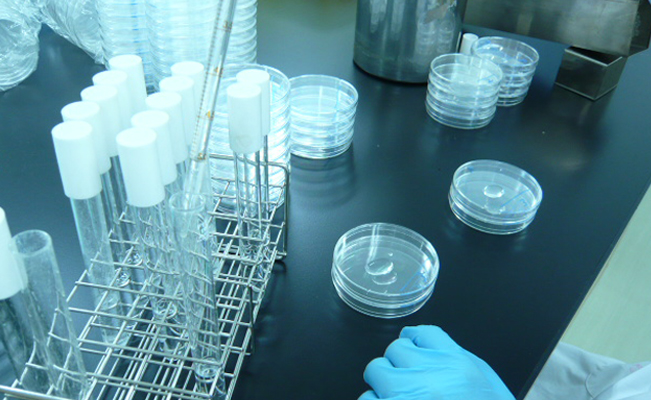
クリーニングの写真04

まるごとクリーニング
見えないところまで美しく。
室内からエンジンルームまで徹底的に洗浄室内外はもちろん、シートを外してニオイの元となる
フロアカーペットまで消臭・除菌を実施。
中古車を気持ちよくお乗りいただけるクリーニングサービスです。

洗浄項目
内装シートを外して、
くまなく洗浄&消臭。
シート・天井・インパネ・トランクまで、洗剤を使ってしっかりクリーニング。特に室内のニオイの元であるフロアカーペットの汚れは、シートを外して徹底洗浄。さらに、消臭・除菌も実施。
※一部シートを外していないクルマもございます。
※洗浄方法は販売店によって異なります。
内装項目
- 取り外し
- ・フロントシート取り外し
※一部シートを外していないクルマもございます。 - 消臭
- ・室内消臭
- 洗浄
- ・フロントシート、リヤシート
- ・ドア・ドアトリム、ヒンジ
- ・天井、シートベルト
- ・フロント・リヤ・サイドガラス内部
- ・フロアカーペット
- ・インパネ、コンソール
- ・フロアマット
- ・トランク
外装ボディ・タイヤはもちろん、
エンジンルームまで積極的に。
ボディの汚れや鉄粉を洗浄し、磨き上げ・コーティング。
タイヤ・ホイール・エンジンルームまで、しっかり洗浄。
外装項目
- 洗浄・磨き
- ・鉄粉除去(上三面)
- ・ボディ全面みがき
- ・ボディシャンプー
- ・タイヤ・ホイール洗浄
- 艶出し
- ・ボディコート
- ・ホイール艶出し
エンジンルーム項目
- 洗浄
- ・エンジンルーム洗浄
- 艶出し
- ・エンジンルーム艶出し
洗浄効果検証
まるごとクリーニングの効果が見える!洗浄効果を目に見えるカタチで検証します。
検証した箇所フロントシート
まるごとクリーニングの洗浄前と洗浄後、それぞれシートの
一部を切り取って、細菌やカビの量を比較検証しました。
検証後
研究カルテ 除菌(カビ)
まるごとクリーニング前と後で比較しました。
- ※検査結果は、車両の状態によって異なる場合もあります。
- ※効果検証を正しく行うため、検体検査を第三者機関に依頼し、公正な結果を掲載しています。
- ■微生物検査および検査画像提供:財団法人食品分析開発センター